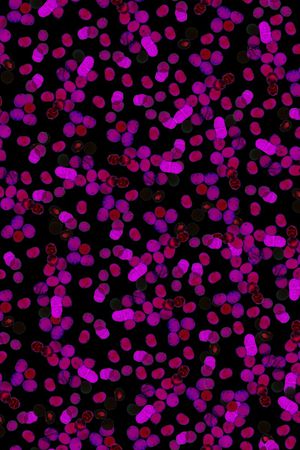
抽象印花华亿平台图片

¥249 (#897289)
¥249 (#897288)
¥249 (#897285)
¥249 (#897284)
¥249 (#897282)
¥249 (#897276)
¥249 (#897274)
¥249 (#897273)
¥249 (#897272)
¥249 (#897271)
¥249 (#897270)
¥249 (#897269)
¥249 (#897267)
¥249 (#897264)
¥249 (#897256)
¥249 (#897253)
¥249 (#897252)
¥299 ~ ¥599 (#897250)
¥249 (#897246)
¥249 (#897237)
¥249 (#897233)
¥249 (#897230)
¥249 (#897228)
¥249 (#897217)
¥249 (#897206)
¥249 (#897205)
¥249 (#897204)
¥249 (#897202)
¥249 (#897200)
¥249 (#897197)